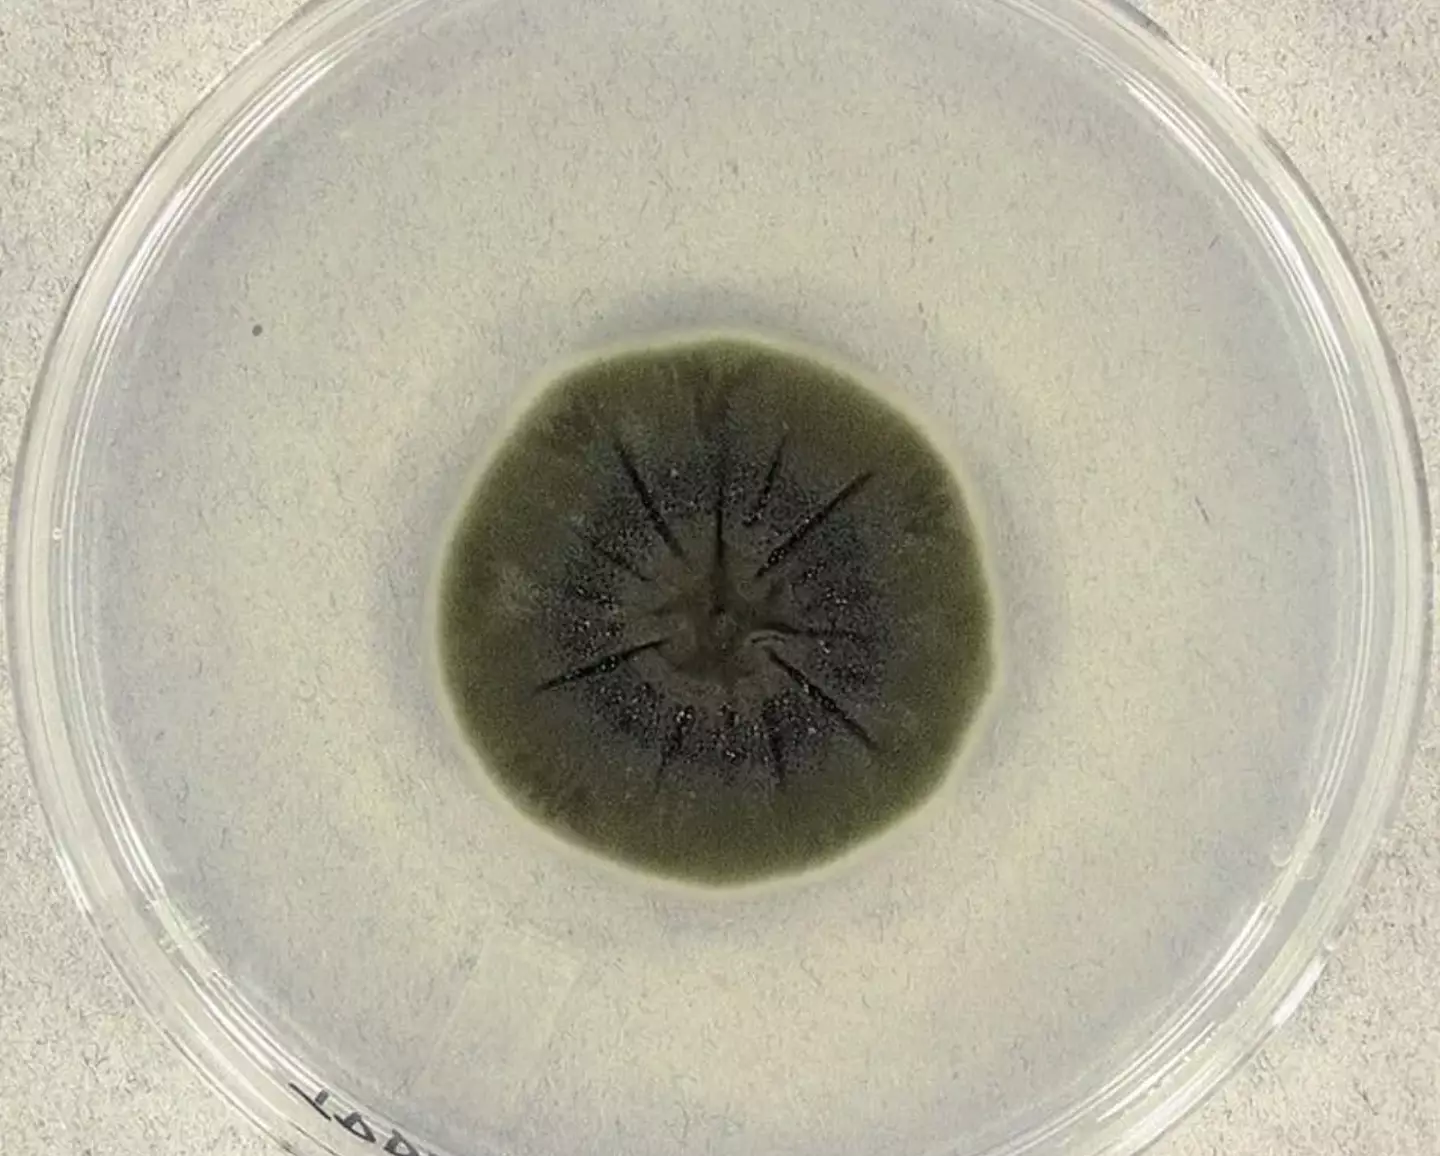

When reactor number four in Chernobyl exploded, it triggered the worst nuclear disaster in history, one which the surrounding area still has not yet recovered from.
After the disaster at the Ukrainian nuclear power plant, scientists working in the ruined remains of reactor four discovered a strange black mould that was growing over the building walls despite the dangerous levels of radiation around it.
Indeed, the radiation actually didn’t seem to be doing much damage to this fungus and it appeared to be growing in environments where no human would be expected to survive.
Indeed, the Royal Society of Biology reckons this friendly fungus is ‘eating gamma radiation for breakfast’, which is a pretty darn cool thing for it to do, after scientists realised that the fungus appeared to be actively seeking out areas with higher radiation.
What is the black fungus discovered in Chernobyl reactor 4?

Reactor number four at Chernobyl is contained, but the area has been profoundly affected
(Brendan Hoffman/Getty Images)
Its official fancy name is ‘Cladosporium sphaerospermum’, which is a more scientific way of referring to the fungus than calling it the black stuff growing on the walls in Chernobyl.
The fungus had been seen and examined a whole century before Chernobyl, but it’s something plenty of people would have stayed away from – although it could actually be pretty useful.
Whatever it might be used for, it’s undeniable that after the Chernobyl disaster this fungus found itself in an environment where it could not just survive but also thrive.
Why does the black fungus consume gamma radiation?

Before Russia’s invasion people could take tours of Chernobyl (SERGEI SUPINSKY/AFP via Getty Images)
Here’s the science-y bit, this black fungus in Chernobyl is part of a family of ‘radiotrophic fungi’ which can feed of ionising radiation, which is quite neat.
A study into the matter found that these fungi could basically eat radiation and use it to keep doing what they’re doing.
It’s somewhat like photosynthesis where plants take in sunlight to fuel their metabolic process, only this time the sunlight is ionising radiation.
It’s known as radiosynthesis, and there’s plenty of radiation to gobble up in Chernobyl.
As for why this all works it seems to be thanks to melanin, that pigment which gives us our skin and eye colours.
The Cladosporium sphaerospermum has a dark shell made of layers of melanin and this takes the energy from the radiation and uses it to grow the fungus.
What does the discovery mean and why it could be a good thing?
It may look sinister but it could actually be a huge help (Medmyco/Wikimedia)
While the idea of a strange black fungus that consumes radiation sounds like the starting point of a particularly sinister film where we get attacked by whatever mutated monster comes out of the fungus, this thing actually seems to be quite a help.
If this fungus can eat radiation then it could be a handy tool in areas affected by the ionising poison, though we shouldn’t expect it to gobble up a nuclear disaster’s worth of radiation.
According to Forbes, some of the fungus has been sent into space for tests aboard the International Space Station in an attempt to work out whether it could help protect astronauts from cosmic radiation.
Even if it can’t undo the damage at Chernobyl, there could be some great uses for it.
News
Scientists Trap Thyme’s Healing Power in Tiny Capsules
A new micro-encapsulation breakthrough could turn thyme’s powerful health benefits into safer, smarter nanodoses. Thyme extract is often praised for its wide range of health benefits, giving it a reputation as a natural medicinal [...]
Scientists Develop Spray-On Powder That Instantly Seals Life-Threatening Wounds
KAIST scientists have created a fast-acting, stable powder hemostat that stops bleeding in one second and could significantly improve survival in combat and emergency medicine. Severe blood loss remains the primary cause of death from [...]
Oceans Are Struggling To Absorb Carbon As Microplastics Flood Their Waters
New research points to an unexpected way plastic pollution may be influencing Earth’s climate system. A recent study suggests that microscopic plastic pollution is reducing the ocean’s capacity to take in carbon dioxide, a [...]
Molecular Manufacturing: The Future of Nanomedicine – New book from Frank Boehm
This book explores the revolutionary potential of atomically precise manufacturing technologies to transform global healthcare, as well as practically every other sector across society. This forward-thinking volume examines how envisaged Factory@Home systems might enable the cost-effective [...]
New Book! NanoMedical Brain/Cloud Interface – Explorations and Implications
New book from Frank Boehm, NanoappsMedical Inc Founder: This book explores the future hypothetical possibility that the cerebral cortex of the human brain might be seamlessly, safely, and securely connected with the Cloud via [...]
Global Health Care Equivalency in the Age of Nanotechnology, Nanomedicine and Artificial Intelligence
A new book by Frank Boehm, NanoappsMedical Inc. Founder. This groundbreaking volume explores the vision of a Global Health Care Equivalency (GHCE) system powered by artificial intelligence and quantum computing technologies, operating on secure [...]
Miller School Researchers Pioneer Nanovanilloid-Based Brain Cooling for Traumatic Injury
A multidisciplinary team at the University of Miami Miller School of Medicine has developed a breakthrough nanodrug platform that may prove beneficial for rapid, targeted therapeutic hypothermia after traumatic brain injury (TBI). Their work, published in ACS [...]
COVID-19 still claims more than 100,000 US lives each year
Centers for Disease Control and Prevention researchers report national estimates of 43.6 million COVID-19-associated illnesses and 101,300 deaths in the US during October 2022 to September 2023, plus 33.0 million illnesses and 100,800 deaths [...]
Nanomedicine in 2026: Experts Predict the Year Ahead
Progress in nanomedicine is almost as fast as the science is small. Over the last year, we've seen an abundance of headlines covering medical R&D at the nanoscale: polymer-coated nanoparticles targeting ovarian cancer, Albumin recruiting nanoparticles for [...]
Lipid nanoparticles could unlock access for millions of autoimmune patients
Capstan Therapeutics scientists demonstrate that lipid nanoparticles can engineer CAR T cells within the body without laboratory cell manufacturing and ex vivo expansion. The method using targeted lipid nanoparticles (tLNPs) is designed to deliver [...]
The Brain’s Strange Way of Computing Could Explain Consciousness
Consciousness may emerge not from code, but from the way living brains physically compute. Discussions about consciousness often stall between two deeply rooted viewpoints. One is computational functionalism, which holds that cognition can be [...]
First breathing ‘lung-on-chip’ developed using genetically identical cells
Researchers at the Francis Crick Institute and AlveoliX have developed the first human lung-on-chip model using stem cells taken from only one person. These chips simulate breathing motions and lung disease in an individual, [...]
Cell Membranes May Act Like Tiny Power Generators
Living cells may generate electricity through the natural motion of their membranes. These fast electrical signals could play a role in how cells communicate and sense their surroundings. Scientists have proposed a new theoretical [...]
This Viral RNA Structure Could Lead to a Universal Antiviral Drug
Researchers identify a shared RNA-protein interaction that could lead to broad-spectrum antiviral treatments for enteroviruses. A new study from the University of Maryland, Baltimore County (UMBC), published in Nature Communications, explains how enteroviruses begin reproducing [...]
New study suggests a way to rejuvenate the immune system
Stimulating the liver to produce some of the signals of the thymus can reverse age-related declines in T-cell populations and enhance response to vaccination. As people age, their immune system function declines. T cell [...]
Nerve Damage Can Disrupt Immunity Across the Entire Body
A single nerve injury can quietly reshape the immune system across the entire body. Preclinical research from McGill University suggests that nerve injuries may lead to long-lasting changes in the immune system, and these [...]















